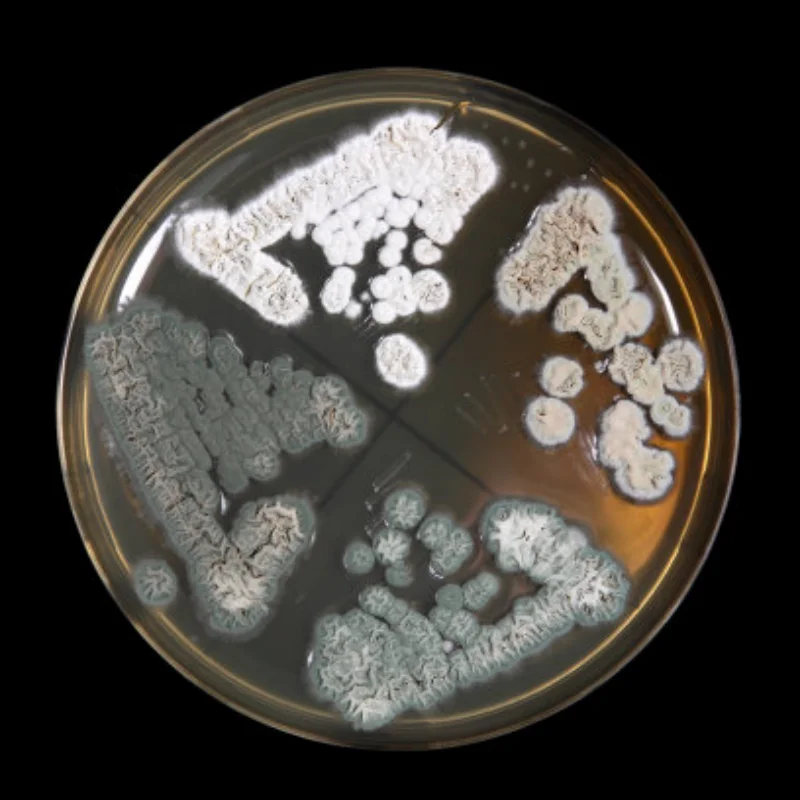
Полный металлический коробка передач SCX10, коробка передач, коробка передач, содержит шестерню для 1/10 радиоуправляемого гусеничного автомобиля, осевые детали для обновления SCX10

Постельное белье! Viluta! Бязь! Бесплатная доставка! 01.12-31.12, Серый


артикул: 1286814436
СОГЛАСНО НАШИМ ДАННЫМ, ЭТОТ ПРОДУКТ СЕЙЧАС НЕ ДОСТУПЕН
750.00 грн.
Доставка из: Украина
Описание
Описание
Бесплатная доставка! С 01.12 по 31.12
Постельное белье! Хорошее качество! Это то, что нужно всем!
Материал: Бязь
Размеры: Полуторка (простынь 215*150, пододеяльник 210*145, наволочки 70*70) – 750 грн
Двуспалка (простынь: 200*220, пододеяльник 180*210, наволочки 70*70) – 850грн
Бесплатная доставка! С 01.12 по 31.12
Постельное белье! Хорошее качество! Это то, что нужно всем!
Материал: Бязь
Размеры: Полуторка (простынь 215*150, пододеяльник 210*145, наволочки 70*70) – 750 грн
Двуспалка (простынь: 200*220, пододеяльник 180*210, наволочки 70*70) – 850грн
Пользователи также просматривали

2,735.98 грн.
Телефонный запас HE910 HE910-G HE910-D Mini PCIe UMTS HSPA+ Встроенный четырехдиапазонный
aliexpress.com
2,577.41 грн.
Red Pointed Toe Slip on Pumps Comfortable Stilettos High Heels High Heel Shoes for Women Sexy Heels 2024 New Zapatos Para Mujere
aliexpress.com
200.60 грн.
DUVO+ Ошейник для кошек нейлоновый "Cool cats", салатовый, 20-30см/10мм (Бельгия)
samizoo.ru
10,167.89 грн.
Стол руководительский Solarius Классика из массива сосны 120х60х75, лакированный, Классика из массива сосны 120х60х75
goods.ru
2,115.96 грн.
Для-A3 8P S-Line 2009-2012 передний бампер, противотуманная лампа, решетки, крышка 8P0807682 8P0807681
aliexpress.ru
1,388.13 грн.
Женские холщовые полутапочки, плоская Вулканизированная подошва, без застежки, кроссовки на платформе
aliexpress.com
2,175.53 грн.
Men's Hollow Tourbillon Automatic Mechanical Watch Glow-in-the-dark Waterproof Watch Fashion Moon-phase Sports Watch
aliexpress.com
922.90 грн.
Electric Sprayer Bottle Lightweight Professional Plant Watering Device for Garden Kitchen Cleaning Outdoor Flower Indoor
aliexpress.com
172.41 грн.
2 Pcs Tent Joint Connectors DIY Support Rod Outdoor Supplies Replacement Poles Repair
aliexpress.ru
2,850.92 грн.
Двойной контроллер управления дроссельной заслонкой, 36-60 в + 48 В, 800 Вт, 6 контактов
aliexpress.ru
1,470.77 грн.
Мужские рабочие защитные ботинки со стальным носком, легкие дышащие противоударные защитные ботинки из натуральной кожи
aliexpress.ru
1,504.75 грн.
Омыватель лобового стекла автомобилей резервуар для воды для Kia MATRIX 2001-2007 9862017000 9861017000 98620-17000, запасные части, аксессуары
aliexpress.ru
110.33 грн.
Очки для плавания для детей, незапотевающие детские очки для плавания с защитой от УФ-лучей и зеркальными очками для детей, подростков, молодежи, для плавания
aliexpress.ru
767.69 грн.
Немецкая ручка Ling Mei, Подарочная коробка Safari, Аутентичные деловые подарки, чернильная Подарочная коробка, оптовая продажа.
aliexpress.ru
730.35 грн.
Защита для радиатора мотоцикла, решетка радиатора, Защитная крышка для радиатора для LONCIN VOGE 500DS 500R 300R VOGE 500 DS
aliexpress.ru
133.40 грн.
Головной убор для Slayer демонов, вязаная шапка, лыжные шапочки, облегающие шапки, шапки Kimetsu No Yaiba Kamado Tanjirou, Весенняя теплая шапка с дьявольским ...
aliexpress.ru
2,190.63 грн.
men's casual shirts male costume clothing fashion model show loose bow oversize shirt plus size costumes, White;black
dhgate.com
929.19 грн.
Court Wind Show Thin Summer Ice Silk Nightgown Women Long Sleeve Pajamas Live With Sexy Lace Leisurewear During The Spring And A
aliexpress.com
3,087.52 грн.
Новинка 2021, внутреннее освещение, регулируемая светодиодная настольная лампа, прикроватный светодиодный светильник для спальни, скандинав...
aliexpress.ru
648.55 грн.
925 Sterling Silver Zircon Silver Earrings Ring Holiday Gifts 2022 New Fashion Frosty Wind High Quality Luxury Boutique
aliexpress.com
302.04 грн.
100 шт., фиксаторы для крышки фотоизоляции для Chrysler,JEEP,Dodge,Ram,4878883AA с 1 шт. приспособлителя для снятия крепежа
aliexpress.com
3,463.39 грн.
MagicKit AMG E63 Style Diamond Front Grille Chrome For Mercedes E Class W212 2014-2016
aliexpress.com
11.33 грн.
1pcs USB Plug Lamp Mini Portable USB LED Book Light Mobile Power Charging LED Eye Protection Reading Light Small Night Lights
aliexpress.com
954.78 грн.
Big Size High Heels Fashion Sexy Cross-tied Mesh Women Heeled Sandals Shoes For Female Pumps Party Ladies Summer Shoes 2022
aliexpress.com
440.06 грн.
2Pcs XH W1209 DC 12V Heat Cool Temperature Control Switch & 1 Pcs Dual NE5532 Replaceable Tone Preamp Board
aliexpress.com
701.82 грн.
Polka Dot Long Handle Straight Umbrella Sunshade And Rain Dual-use Umbrella Girls Simple Parasol Semi-automatic Women Umbrella
aliexpress.com
170.32 грн.
Автоматический возврат мяча для гольфа тренировочное устройство для тренировки в помещении аксессуары для спорта на открытом воздухе
aliexpress.ru
1,509.78 грн.
ruched denim blue high wait stacked pants autumn women clothing punk gothic streetwear jeans fashion skinny pockets trousers
dhgate.com
763.91 грн.
High quality 99% pure Resveratrol Powder anti-cancer Supplement body resveratrol extract Antioxidant beauty skin nmn free shipp
aliexpress.com
29.78 грн.
Toilet Brush and Holder Creative Lovely Cherry Shape Lavatory Brush Toilet Brush Bathroom Toilet Brush Holder Set Clean Tool
aliexpress.com
297.43 грн.
Clothes Storage Bag Multi Purpose Quilt Blanket Bags 1Pcs 3Colors Home Organizer PEVA Waterproof High Capacity Cartoon Printing
aliexpress.com
2,894.55 грн.
10pcs/lot for 3DS XL LL for 3DSXL for 3DSLL top upper lcd display screen original new
aliexpress.com
21,561.46 грн.
by dhl 1000pcs 24cm Round Non-stick Mat Pan Fry Liner Sheet BBQ Baking Mats tools Cooking Wok Sheet Kitchen Baking Pad
aliexpress.com